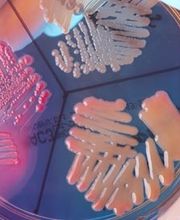
Gallery Cliente

Chiama ora!
Agri Bio Search
+390755990535 (Telefono)
+390755990535 (Fax)
Novità e Offerte
Info
Laboratorio Agribiosearch, centro analitico altamente specializzato e qualificato, offre un servizio completo di Analisi Chimiche, Microbiologiche e Biomolecolari per la Sicurezza e la Qualità di tutta la Filiera Agroalimentare e del Sistema Ambientale. Filiera Agroalimentare: acque, analisi potabilità, controllo piscine, analisi terreni, valutazione della micorrizzazione, mangimi e pet food, farine, analisi nutrizionali, etichette nutrizionali, olii e grassi, olio di oliva, analisi microbiologiche, analisi biomolecolari in PCR-RT, ricerca OGM, analisi multiresiduali, consulenze e analisi secondo protocolli HACCP, piani HACCP. Sistema Ambientale: acque reflue, scarichi industriali, percolati di discariche, pozzi, falde, fanghi industriali, suoli, terra e rocce da scavo, caratterizzazione di rifiuti, attribuzione codici CER, cosmetici, controllo qualità delle materie, monitoraggio di discariche, rischio chimico. Consulenze agronomiche, ambientali, igiene e qualità degli alimenti.
Check
Orari di apertura
- Lunedì
- 09:00 a 18:00
- Martedì
- 09:00 a 18:00
- Mercoledì
- 09:00 a 18:00
- Giovedì
- 09:00 a 18:00
- Venerdì
- 09:00 a 18:00
- Sabato
- Chiuso
- Domenica
- Chiuso
Galleria

Mappa
Via Adriatica, 111/E, 06135 Ponte San Giovanni